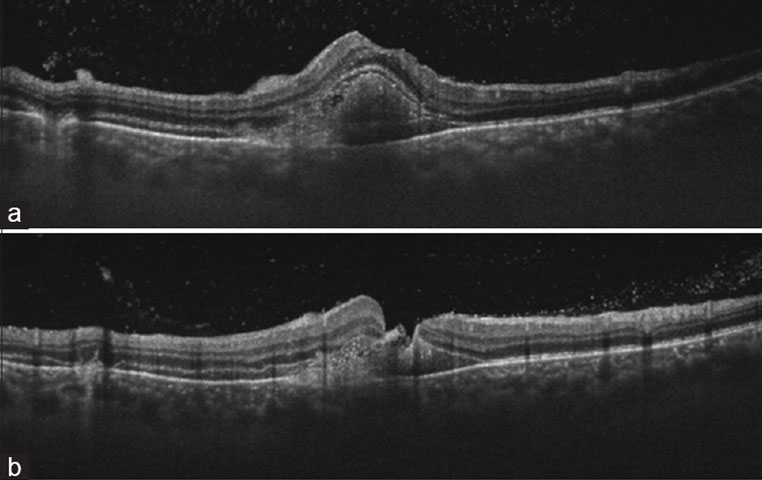
optical-coherence-tomography Delayed surgical management for macular hole with submacular hemorrhage

Bilateral peripapillary myelinated nerve fiber in a case of Stargardt’s phenotype
A 52-year-old male presented with bilateral peripapillary myelinated nerve fibers (pMNFs) along with foveal atrophy surrounded by a ring of whitish-fleck-like lesions.

Bilateral macular retinochoroidal excavation in a case of presumed atypical retinitis pigmentosa
A 21-year-old female, from low socioeconomic background, presented with a diminution of vision in both eyes for 4 years or contributory family history.

Optic nerve head hypoplasia in a presumed case of retinopathy of prematurity
Although ONH hypoplasia occurs more frequently in prematurity, not enough literature has been published on the association of retinopathy of prematurity…
Delayed surgical management for macular hole with submacular hemorrhage
Although a traumatic macular hole (MH) can be observed initially (2-6 months) anticipating spontaneous closure (20-60%), a delay in the management of submacular…

An Update on Fundus Autofluorescence
This imaging method can help elucidate retinal disease, monitor progression and possibly advance therapy…

Presumed tubercular choroidal nodule following adalimumab therapy for juvenile idiopathic arthritis
A 14-year-old boy, known patient of juvenile idiopathic arthritis…

Ischemic macular hole in central retinal artery occlusion
(a and b) Color fundus photo of the right eye 1 day (a) and 20 days (b) after diminution in vision…

Is immediate treatment necessary for diabetic macular edema after pars plana vitrectomy for tractional complications of proliferative diabetic retinopathy?

Circumscribed choroidal hemangioma in a case of neurofibromatosis type 1
(a) External examination showing left upper eyelid plexiform neurofibroma with severe ptosis…

Foveal photoreceptor disruption in ocular diseases: An optical coherence tomography-based differential diagnosis
Fovea centralis, located at the center of the macula, is packed with cone photoreceptors…

Outcomes of vitreoretinal surgery in retinal detachment associated with morning glory disc anomaly
Purpose: Morning glory disc anomaly (MGDA) is associated with a high prevalence of retinal detachment (RD)…

Spontaneous closure of macular hole with conversion to type 2 choroidal neovascular membrane in a case of Vogt Koyanagi Harada disease.

